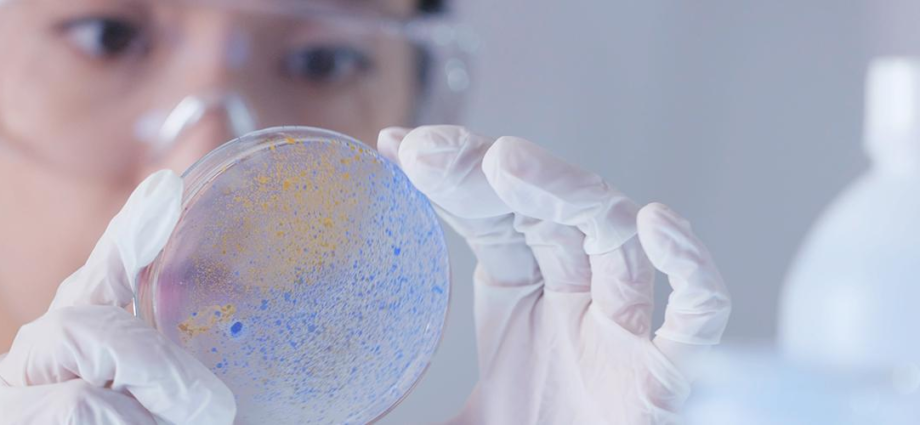

Día Internacional de la Mujer y la Niña en la Ciencia: 11 de febrero

Fuente: Naciones Unidas
Mujeres en el liderazgo de las ciencias: Una nueva era para la sostenibilidad
Abordar algunos de los mayores retos de la Agenda para el Desarrollo Sostenible —desde la mejora de la salud hasta la lucha contra el cambio climático — pasa por sacar partido de todos los talentos disponibles. Esto significa que necesitamos que más mujeres trabajen en estos ámbitos. La diversidad en la investigación amplía la reserva de investigadores con talento, aportando nuevas perspectivas, talento y creatividad. Este Día es un recordatorio de que las mujeres y las niñas desempeñan un papel decisivo en las comunidades científicas y tecnológicas y de que debe reforzarse su participación.
A pesar de que los ámbitos de la ciencia, tecnología, ingeniería y matemáticas (STEM, por sus siglas en inglés) se consideran fundamentales para las economías nacionales, hasta ahora la mayoría de los países, independientemente de su nivel de desarrollo, no han alcanzado la igualdad de género en este sector.
¿Por qué dedicamos un día a la mujer y la niña en la ciencia?
La igualdad de género ha sido siempre un tema central de las Naciones Unidas. La igualdad entre los géneros y el empoderamiento de las mujeres y las niñas contribuirán decisivamente no solo al desarrollo económico del mundo, sino también al progreso respecto de todos los objetivos y metas de la Agenda 2030 para el Desarrollo Sostenible.
El 14 de marzo de 2011, la Comisión de la Condición Jurídica y Social de la Mujer aprobó el informe en su 55º período de sesiones, con las conclusiones convenidas sobre el acceso y la participación de la mujer y la niña en la educación, la capacitación y la ciencia y la tecnología, incluida la promoción de la igualdad de acceso de la mujer al pleno empleo y a un trabajo decente. El 20 de diciembre de 2013, la Asamblea General aprobó la resolución relativa a la ciencia, la tecnología y la innovación para el desarrollo, en que reconoció que el acceso y la participación plenos y en condiciones de igualdad en la ciencia, la tecnología y la innovación para las mujeres y las niñas de todas las edades eran imprescindibles para lograr la igualdad entre los géneros y el empoderamiento de la mujer y la niña.
La Asamblea General declaró el 11 de febrero Día Internacional de las Mujeres y las Niñas en la Ciencia en reconocimiento al papel clave que desempeñan las mujeres en la comunidad científica y la tecnología. En su resolución del 22 de diciembre de 2015, el órgano de las Naciones Unidas dónde están representados todos los Estados Miembros aprobó una resolución en la que justificaba la proclamación de este Día Internacional y alababa las iniciativas llevadas a cabo de la Organización de las Naciones Unidas para la Educación, la Ciencia y la Cultura (UNESCO), la Entidad de las Naciones Unidas para la Igualdad de Género y el Empoderamiento de las Mujeres (ONU Mujeres), la Unión Internacional de Telecomunicaciones (UIT) y otras organizaciones competentes para apoyar a las mujeres científicas y promover el acceso de las mujeres y las niñas a la educación, la capacitación y la investigación en los ámbitos de la ciencia, la tecnología, la ingeniería y las matemáticas.
La igualdad de género ha sido siempre un tema central de las Naciones Unidas. La igualdad entre los géneros y el empoderamiento de las mujeres y las niñas contribuirán decisivamente no solo al desarrollo económico del mundo, sino también al progreso respecto de todos los objetivos y metas de la la Agenda 2030 para el Desarrollo Sostenible.
El 14 de marzo de 2011, la Comisión de la Condición Jurídica y Social de la Mujer aprobó el informe en su 55º período de sesiones, con las conclusiones convenidas sobre el acceso y la participación de la mujer y la niña en la educación, la capacitación y la ciencia y la tecnología, incluida la promoción de la igualdad de acceso de la mujer al pleno empleo y a un trabajo decente. El 20 de diciembre de 2013, la Asamblea General aprobó la resolución relativa a la ciencia, la tecnología y la innovación para el desarrollo, en que reconoció que el acceso y la participación plenos y en condiciones de igualdad en la ciencia, la tecnología y la innovación para las mujeres y las niñas de todas las edades eran imprescindibles para lograr la igualdad entre los géneros y el empoderamiento de la mujer y la niña.
La Asamblea General declaró el 11 de febrero Día Internacional de las Mujeres y las Niñas en la Ciencia en reconocimiento al papel clave que desempeñan las mujeres en la comunidad científica y la tecnología. En su resolución del 22 de diciembre de 2015, el órgano de las Naciones Unidas dónde están representados todos los Estados Miembros aprobó una resolución en la que justificaba la proclamación de este Día Internacional y alababa las iniciativas llevadas a cabo de la Organización de las Naciones Unidas para la Educación, la Ciencia y la Cultura (UNESCO), la Entidad de las Naciones Unidas para la Igualdad de Género y el Empoderamiento de las Mujeres (ONU Mujeres), la Unión Internacional de Telecomunicaciones (UIT) y otras organizaciones competentes para apoyar a las mujeres científicas y promover el acceso de las mujeres y las niñas a la educación, la capacitación y la investigación en los ámbitos de la ciencia, la tecnología, la ingeniería y las matemáticas.
¿Sabías que…?
- Las mujeres suelen recibir becas de investigación más modestas que sus colegas masculinos y, aunque representan el 33,3% de todos los investigadores, sólo el 12% de los miembros de las academias científicas nacionales son mujeres.
- En campos de vanguardia como la inteligencia artificial, donde solo uno de cada cinco profesionales (22%) es una mujer.
- A pesar de la escasez de competencias en la mayoría de los campos tecnológicos que impulsan la Cuarta Revolución Industrial, las mujeres siguen representando sólo el 28% de los licenciados en ingeniería y el 40% de los licenciados en informática y computación
- Las investigadoras suelen tener carreras más cortas y peor pagadas. Su trabajo está poco representado en las revistas de alto nivel y a menudo no se las tiene en cuenta para los ascensos.
![]()